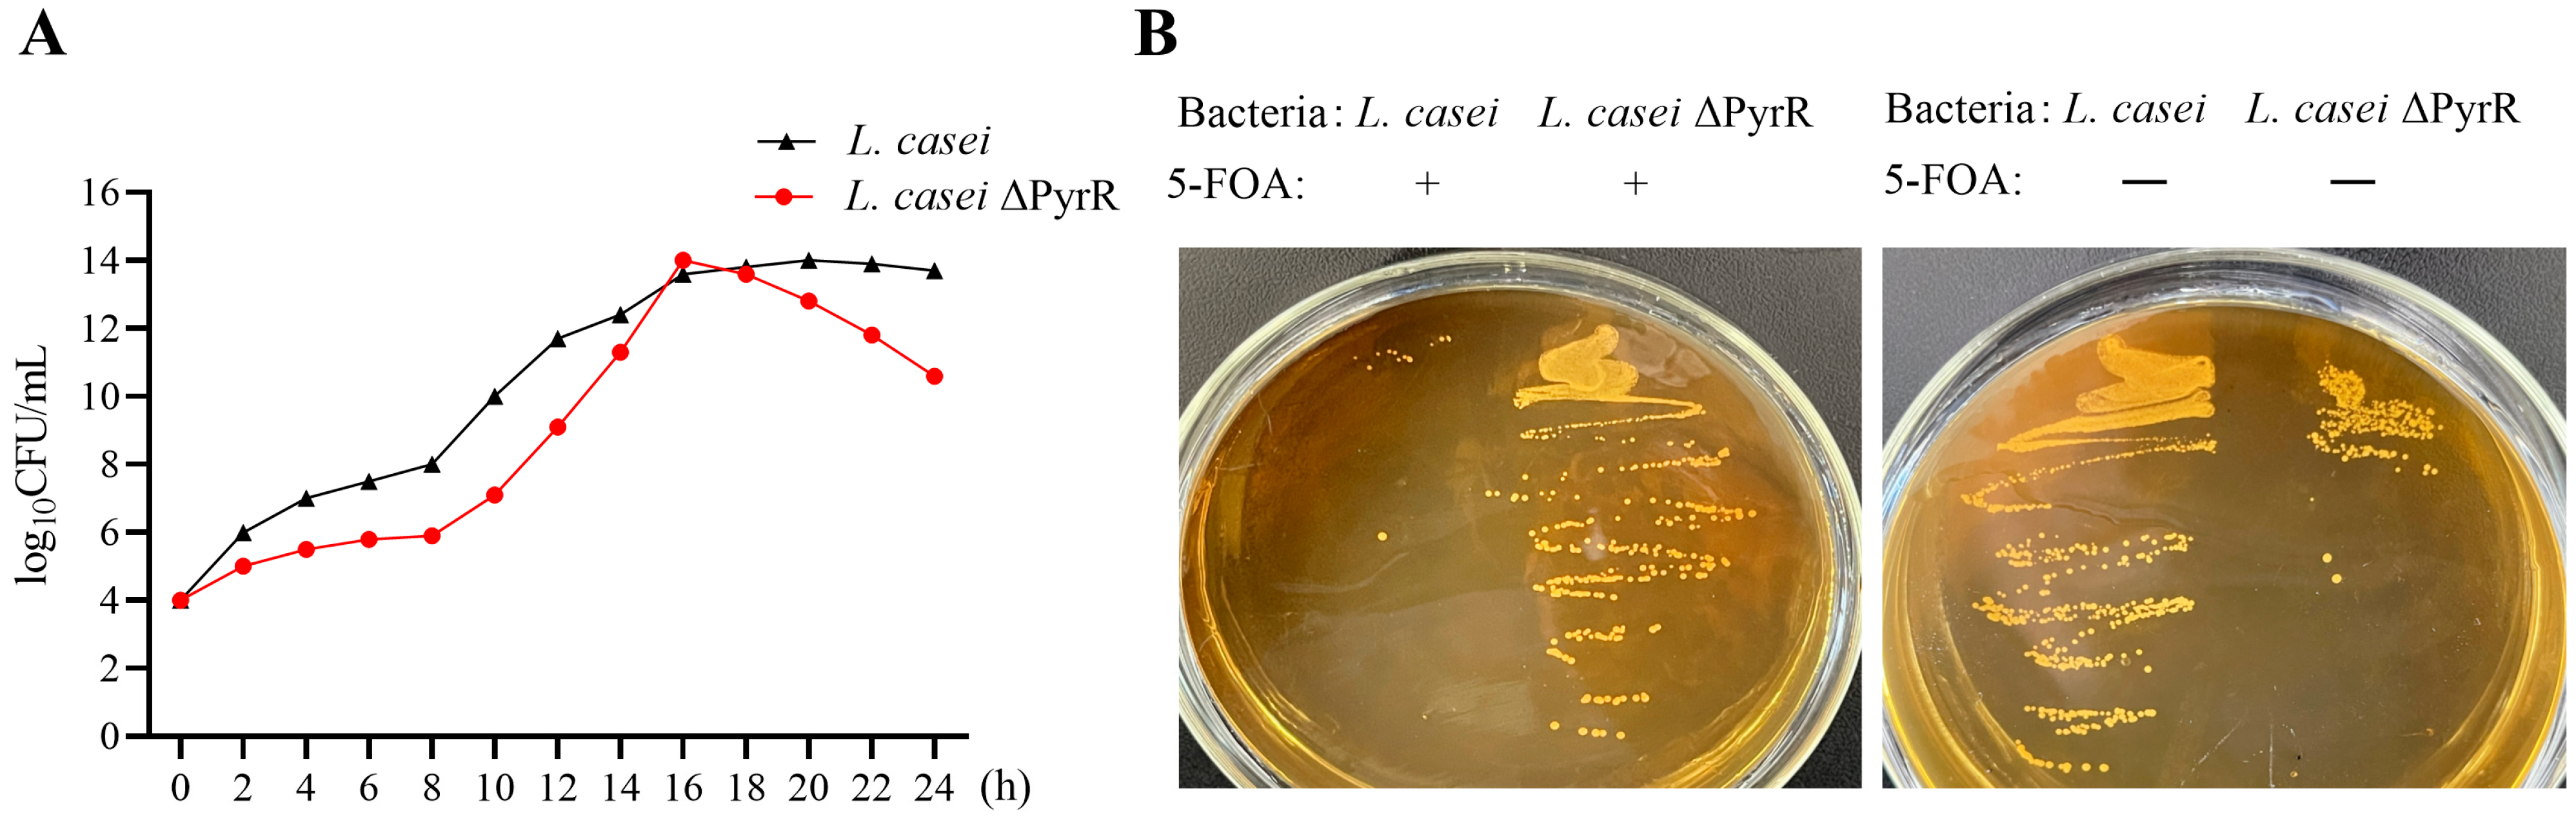
Microorganisms 11 02371 g002

1. Introduction
Lactic acid bacteria (LAB) are a heterogeneous group of Gram-positive bacteria with probiotic functions and a high tolerance for low pH. Live lactic acid bacteria have favorable effects on human and animal health. One study indicated that probiotics significantly reduced antibiotic-associated diarrhea by 52% and acute diarrhea of various causes by 34% [
1]. Molecular and genetic studies have allowed for the determination of the basics of pathogen inhibition with probiotics via four mechanisms: antimicrobial antagonism from metabolic products, competition with pathogens for adhesion, immunoregulation [
2], and the inhibition of bacterial toxins [
3]. Various studies have indicated that LAB inhibit the growth of pathogenic microorganisms and degrade mycotoxins. LAB are abundantly found during the removal and degradation of different types of microorganisms, and they act by disrupting and changing the permeability of the plasma membrane, producing metabolites, and inhibiting protein translation. However, the optimum growth of LAB necessitates complex nutritional requirements for amino acids, peptides, nucleotide bases, vitamins, minerals, fatty acids, and carbohydrates. Meanwhile, LAB can also produce a variety of products, including short-chain fatty acids, amines, bacteriocins, vitamins, and exopolysaccharides, during its metabolism. The concrete antibacterial mechanisms of LAB are complicated, and this sense of complicatedness has been attributed to their ability to produce antimicrobial compounds, including bacteriocins, with strong competitive action against many microorganisms [
4]. The proteomics of probiotics provide a special reference and tool through which we can analyze lactic acid bacteria to better understand their metabolic function in order to answer questions regarding basic cell functions. Nevertheless, single and multiple omics techniques may allow us to gain mechanistic insights and discover new metabolic properties with respect to LAB.
Genome editing tools can be used to overcome existing challenges in all of these perspectives of traditional, emerging, and future applications of lactic acid bacteria. The genome editing tools for LAB focus on a fast speed, clean and targeted modifications, and stable genomic genotypes for a wide variety of strains, which are crucial for the construction of strains for fundamental studies, applications, and products. Most metabolic reactions in LAB are connected via the utilization of nucleotides or in their metabolite regulation of nucleotides, such as in pyrimidine and purine metabolism. The detection of novel pyrimidine derivatives represents a promising area for new antibacterial drug discovery. These derivatives are the means by which one can interact with genetic materials, enzymes, and other biopolymer substances in the cell. Pyrimidine-containing agents represent major areas in the search for new antibacterial drugs due to their strong activities and diverse mechanisms, which represent an advantage in endogenous substances and in the derivatives that interact with genetic materials, enzymes, and other biopolymer substances in the cell [
5]. The formation of pyrimidines has been found to occur in different steps in the biosynthetic pathway of LAB, as well as in the biosynthetic genes of pyrimidine that are scattered on the chromosome of the L. lactis subspecies for five transcriptional units [
6]. The inactivation of PyrR in
Lactococcus lactis may result in a three- to eight-fold de-repression in the expression of all of the pyrimidine biosynthetic genes that play an attenuating mechanistic role with the PyrR regulon [
7]. Given that the PyrR from
B. subtilis possesses significant enzymatic activity in vitro and in vivo [
8], in previous studies, no research was conducted on metabolic regulation regarding the inactivation gene method in the PyrR of
lactobacillus. The deletion of the PyrR gene via genome editing using CRISPR-CAS9 provided the possibility to assess the regulating activity of pyrimidine biosynthesis in LAB.
In this study, we used the systematic biochemical properties of CRISPR-Cas9D10A in order to engineer it into an efficient genome editing tool for Lactobacillus casei. We combined rational engineering and constructed a PyrR-deficient Lactobacillus casei strain that is able to decrease the production of the pyrimidine analog, which also extensively interferes with the growth on different pathogenic bacteria. Moreover, we identified that the pyrimidine analog exhibits immunoregulatory activity in the PBMC. The aim of our study is to provide an overview of the physiology and antibacterial effects of nucleotide metabolism and its regulation, which will facilitate the interpretation of data arising from genetics, metabolomics, proteomics, and transcriptomics in Lactobacillus casei.
3. Discussion
Probiotics, strains containing Bifidobacterium and Lactobacillus, are the predominant groups of the gastrointestinal microbiota. Pharmabiotics, postbiotics, and next-generation probiotics are considered as a means to prevent oxidative stress, inflammatory processes, and neurodegenerative and viral diseases through gut microbiome regulation [
9]. They have considerable potential for preventive or therapeutic applications in various intestinal diseases. However, most probiotic health claims have not yet been substantiated by experimental evidence via the enzymatic and genetic regulation of different lactic acid bacteria. In addition, the efficacy demonstrated by one given bacterial strain cannot necessarily be transferred to other probiotic organisms. In our study, the interpretation of methods arising from genetics, metabolomics, and proteomics have provided the opportunity to investigate the mechanisms that underlie the action of lactic acid bacteria, such as adhesion to intestinal mucosa, the competitive exclusion of pathogenic microorganisms, and the production of antimicrobial substances. All of these mechanisms should build the interaction of probiotics with the host-associated immune system. Our research involved constructing a PyrR-deficient
Lactobacillus casei strain that is able to decrease the production of the pyrimidine analog, which further extensively interferes with growth on different pathogenic bacteria.
The five transcriptional units—carB [
10], pyrRPBcarA [
7], pyrEC, pyrKDbF [
11], and pyrDa [
12]—for pyrimidine biosynthetic genes are scattered on the chromosome of L. lactis subsp. A pyrR gene encoding a regulatory protein was found to be the first gene of the pyrRPBcarA operon, which has been shown to decrease the expression of all pyrimidine biosynthetic genes by three- to eight-fold in
Lactococcus lactis [
7]. The pyrimidine biosynthetic pathway is initially formed from the formation of carbamoyl phosphate (CP), which also catalyzes the conversion of DHO to orotate with the carAB-PyrB-PyrC-PyrD cassette. Orotic acid, cytosine (C), uracil (U), thymine (T), cytidine (CR), and uridine (UR) are converted to UMP, thereby producing the end-products of pyrimidine in the biosynthetic pathway. Site-directed mutagenesis reduced the UTP and CTP pools that were regulated by transcription attenuation and mediated by a trans-acting repressor in
Lactobacillus plantarum [
13]. The PyrR-type attenuators were found upstream of all the pyrimidine biosynthetic genes, which can be identified in most lactobacilli, except those in
L. casei. Our study developed the widely applicable and efficient PyrR-based CRISPR-Cas system in
L. casei for whole genetic deletion, which provided novel insights into the molecular mechanisms of the PyrR gene in relation to the antimicrobial antagonism of metabolic products, competition with pathogens for adhesion, and immunoregulation. The molecular docking results indicated that the pyrR protein attenuates the virulence of biofilm formation and targets the de novo pyrimidine synthesis pathway in S. aureus [
14]. To increase the sensitivity of 5-FOA, the double-mutant strain ΔpyrF ΔpyrR in
Geobacillus kaustophilus was constructed. It was auxotrophic for uracil and resistant to 5-FOA [
15]. The parasite PyrR activity was nonspecific and active with respect to uridine, deoxyuridine, pyrimidine, and thymidine.
As a result, the selection (uracil auxotroph) and counterselection (5-FOA) markers can be utilized for developing CRISPR-Cas systems for broad and convenient clinical applications with
L. casei strains. Additionally, there was no effect on the growth performance in the strains that contained PyrR deletions, which were uracil-auxotrophic hosts. The CRISPR-Cas9-based genome editing system combined with pyrF/5-FOA is both time-saving and efficient with respect to developing gene editing systems for a variety of A. baumannii strains [
16]. Moreover, these genetic manipulation methods unveil the drug resistance of oxidative stress-sensing mechanisms within the OxyR gene via the performance of a H
2O
2-sensing pocket in an A. baumannii strain. The reduced pyrimidine outside the lactobacillus in mutant bacteria likely reflects differences in PyrR-induced cytotoxicity, which are then exported to the cell surface in the SEM results. In contrast, the disruption of PyrR in the
L. casei ΔPyrR strain produced severe uracil auxotrophy due to the loss of the de novo pyrimidine synthesis pathway. These findings reveal the importance of ubiquitous surface modifications for PyrR function, which explain the broad lactobacillus colonization and processes that underlie host–pathogen interactions and also highlight the utility of genome-wide CRISPR/Cas9 screenings with respect to explaining their probiotic role.
Today, ineffective first-line antibiotics, emerging pathogenic bacteria, and reduced immunity are becoming critical reasons for the clinical death of patients. Therefore, novel antimicrobial agents from probiotics are urgently needed in the field of drug discovery. These agents have attracted the attention of scientists due to their remarkable biological activity, i.e., their use in anticancer, antiviral, antimicrobial, anti-inflammatory, analgesic, antioxidant, and antimalarial therapies. They are characterized by bacteriocins, hydrogen peroxide, and diacyls, which prevent the proliferation of glucose and inhibit growth [
17]. The most famous of these agents are antimicrobial compounds, and pyrimidines, as an integral part of DNA and RNA, play an important role in drug discovery projects with pharmacological and chemical significance [
5]. Pyrimidine analogue are classified many heterocycles in antimicrobial drug discovery, and they first attracted our attention due to the remarkable pyrimidine pool in probiotics. The metabolites interact with diverse protein targets in pathogenic microorganisms, leading to the inhibition of FtsZ polymerization, GTPase activity, and bacterial cell division [
18]. Furthermore, 5-Fluorouracil was used in a phase III clinical trial as an antibacterial agent [
19]. Many Gram-positive and Gram-negative bacteria were found to be susceptible to floxuridine [
20]. Additionally, Gram-positive
Streptococci,
S. aureus, and
Bacillus species were more sensitive than Gram-negative bacteria, while the same trend was also found for
L. casei’s antibacterial activity in our test. An encouraging example of metabolic engineering in Pseudomonas putida resulted in the improvement of microbial bioconversion for ferulic acid consumption via an efficient genome editing strategy [
21]. The deletion of a gene that encodes a protein molecule of 1,3-propanediol reductase
in L. reuteri decreased the production of reuterin when compared to the wild strain, which was identified as a novel antimicrobial variant for killing
E. coli [
22]. Regarding synthetic biology developments, there was an improvement in the regulatory control systems, with the silencing and deletion of the host of lactic acid bacteria metabolites controlling gene expression in vivo at the targeted location with genome editing [
23,
24]. The programmable autolysis and killing of specific pathogens have been genetically engineered in the bacterial reprogramming of
E. coli [
25,
26] and could be adapted to LAB. Most importantly, a court recently ruled that new genome editing methods (including CRISPR-Cas), as ‘non-GMO’ techniques, have recently been greenlit for use in the USA for Cas9-edited plants [
27]. LAB could also be considered as microbial cell factories in the development of traditional industrial biotechnologies with green chemical production, which would create an iterative workflow of “Design–Build–Test–Learn”.
The modification of native genes in probiotics could be one approach to enhance the immunomodulation properties of hosts. Although the overall mechanistic understanding of probiotic features in the context of immunoregulation is still mostly lacking, their key role in probiotic metabolites and outer cell surfaces is in the interaction with the probiotic host. Teichoic acids (TAs) stimulate TLRs in mammalian hosts in order to promote dendritic cell differentiation, which subsequently leads to cytokine responses [
28] and the D-alanylation of Tas, which decreases the adhesion of
L. reuteri to host cells [
29]. In another study, the deletion of the phosphoglycerol transferase gene was enacted upon the biosynthesis of lipoteichoic acid (LTA) in
Lactobacillus acidophilus. In addition, the LTA-deficient strain relieved colonic polyposis in a unique mouse model when compared with wild-type
L. acidophilus [
30].
Regarding our study, we conclude that pyrimidine biosynthesis modulates the intracellular nucleotide pools to maintain metabolic homeostasis, thus quenching the host’s innate immunity during biotrophy. The nucleotidyltransferases (CD-NTases) in bacteria were capable of synthesizing the cyclic pyrimidine in bacterial physiology and the modulation of the host’s innate immune system [
31]. Moreover, the V. cholerae encoded di-nucleotide cyclase (DncV) works to synthesize the cyclic AMP-GMP molecule, which also plays a beneficial role in the host adaptation and intestinal colonization processes [
32]. These pyrimidine adducts are microbial small molecules that are derived from metabolic pathways to activate the mucosal-associated invariant T cell (MAIT) for immunosurveillance [
33]. Most importantly, Toxoplasma gondii KU80 has been used to delete the orotidine-5′-monophosphate decarboxylase (OMPDC) and uridine phosphorylase (UP) genes to obtain an avirulent non-reverting pyrimidine auxotroph strain, providing novel tools for the dissection of the host Th1 immune response with respect to infection [
34]. Our study also analyzed the functional capacity of the pyrimidine pathways by deleting the PyrR salvage activity in
Lactobacillus casei, which controls the direct access to the host cell pyrimidine biosynthetic pathway with or without pyrimidine interacting with the host’s immune cells, which indicates that pyrimidine stimulated peritoneal macrophage polarization in the mice.
Overall, the examples we have provided illustrate how, for food-grade bacteria in general and probiotic lactobacilli to be identified as novel variants, genetic engineering approaches work to promote human health. As long as the application of CRISPR-based technologies continues to expand the genetic toolboxes for LAB, we believe that LAB will have the potential to modulate microbiota and host immunity. In particular, the genome editing of LAB will be much more effective in terms of eradicating the target microbes in new specific strains. Advancements in this field must be accompanied by the consideration of matters and topics such as the ongoing CRISPR intellectual property battles, the enabling of technological advances in LAB, biological safety, policies and regulations, and consumer acceptance. Nonetheless, the ongoing microbiology renaissance, fueled by CRISPR technological advances and our increasing awareness of LAB, remains strong.
4. Materials and Methods
4.1. Bacterial Strains and Plasmids
The
Lactobacillus casei was separated from Min pig, which was cultured in MRS broth (Sigma, St. Louis, MO, USA) without shaking at 37 °C. The antibiotic concentration was 10 mg per liter with erythromycin in MRS media. Competent cells of
E. coli TG-1 were used as the cloning host. All
E. coli harboring pCLNICK series plasmids grew on the LB media with kanamycin (50 mg/L) at 32 °C. The
Lactobacillus casei gene-editing plasmid pLCNICK was kindly supplied by Yang Sheng (Key Laboratory of Synthetic Biology, CAS, Shanghai, China). All the bacterial strains and plasmids for cloning, as well as the
L. casei and
L. casei ΔPyrR mutants used in this study, are listed in
Table 2.
4.2. Plasmid Construction of PyrR-Deficient L. casei by CRISPR-Cas9D10A
All of the steps of gene cloning and plasmid construction are shown in
Figure 7. According to the general principles of primer design, the PyrR gene and up/down homology arms were cloned with the up-stream/down-stream primer. The pyrimidine regulatory gene (PyrR) was cloned as the target gene from
Lactobacillus casei. The PyrR and the upstream/downstream homology arms (HASup and HASdown) were amplified via PCR. The PCR product (HASup-PyrR-HASdown) was connected to the cloning vector of pMD19, which was used as the template to clone the HASup and HASdown genes. Both the HASup and HASdown genes were cloned into the cloning vector. The cloning HASup and HASdown genes were connected via fusion PCR, the PCR product of which was cloned into pMD19. To construct pMD19-sgRNA-HASup-HASdown for genome deletion, the sgRNA was connected to a single fragment of HASup-HASdown via overlap extension PCR. The resulting cassette of sgRNA-HASup-HASdown with XbaI and ApaI restriction endonuclease sites was ligated to a cloning vector of pMD19. To generate the genome-editing plasmid, which was named pLCNICK-PyrR-HAS-sgRNA, the backbone of the P23 promoter for Cas9
D10A (Em
r), the promoter of Pldh for sgRNA (sgRNA), and Has (obtained via the restriction endonuclease of XbaI and ApaI from the pMD19-sgRNA-HASup-HASdown plasmid) were used. All of these recombinant plasmids were chemically transformed into competent cells of
E. coli TG1.
4.3. Transformation of Lactobacillus casei for Electroporation
The constructed plasmids were transformed into L. casei via electroporation. Competent cells of L. casei were prepared according to the following protocol: In total, 2 mL of L. casei was cultured into a 100 mL MRS+ 2% glycine media and incubated overnight at 37 °C until the optical density in the logarithmic phase was reached without shaking at 5000 rpm and at 4 °C. The L. casei cells were chilled on ice for 10 min and harvested via centrifugation at 5000 rpm and 4 °C for 10 min, washed twice with 40 mL of ice-cold EPWB (NaH2PO4 0.6 mmol/L, MgCl2 0.1 mmol/L), and then washed once in 40 mL of ice-cold EPB (NaH2PO4 0.6 mmol/L, MgCl2 0.1 mmol/L, 0.3 mol/L Sucrose). The L. casei cells were centrifuged for 10 min at 5000 rpm and 4 °C. The iced L. casei competent cells were resuspended with 1 mL of EPB, which was used prior in electroporation.
Competent cells of L. casei were mixed with 1 μg of the plasmid pLCNICK-PyrR-HAS-sgRNA and subsequently transferred into a precooled 2 mm electroporation cuvette at 2.2 kV, 200 Ω, and 25 μF with a Bio-Rad GenePulser Xcell. The precooled MRS+ 500 mM sucrose broth (1 mL) was immediately added to the electroporation cuvette, which was then transferred to a culture tube to recover growth for 5 h at 37 °C without shaking. The recovered cells were grown on MRS plates containing erythromycin (5 μg/mL) for 4 or 5 days, and single colonies were randomly selected for growth in MRS broth containing erythromycin (5 μg/mL). All colonies were used to extract the genome as the template determining the PyrR was knocked out using the PCR method. The L. casei mutation strain with the PyrR gene deletion in its genome was constructed to identify the positive clone (named L. casei ΔPyrR). All of the PCR products obtained from identifying the positive clone were sequenced to confirm the deleting strain.
4.4. Prokaryotic Expression of Recombinant Plasmid and Its Anti-Mice PyrR Protein Polyclonal Antibody Preparation
The recombinant protein of PyrR was expressed by the expressing vector of Cold Shock Expression System pCold™ DNA (Takara Bio Inc., Kusatsu, Shiga, Japan), and the recombinant proteins were induced via IPTG and purified using the His-tag Protein Purification Kit (Beyotime, Shanghai, China). The purified protein was immunized in mice to produce an anti-mice PyrR protein polyclonal antibody, which was taken from the serum of mice that was used in the Western Blot analysis part of our study.
4.5. Batch Fermentation, Growth Curve, and Lactic Acid Production
Fermentation was carried out in 100 mL of MRS media in 250 mL Erlenmeyer flasks. The L. casei and L. casei ΔPyrR strains were statically cultivated in a MRS medium at an initial density OD600 of 0.05 (MRS Broth, Becton, Dickinson and Company, New York, NY, USA). The cells of the cultures were incubated at 37 °C without shaking. For time course experiments, the samples were taken every 2 h for an analysis of the bacterial population density.
4.6. Determination of 5-FOA Susceptibility
The strains L. casei and L. casei ΔPyrR were cultivated on solid MRS plates that consisted of 5-FOA in amounts of 250 μmol/L. The L. casei and L. casei ΔPyrR strains were incubated on MRS plates at 37 °C for 3–4 days. The growth and morphology of the colonies that were incubated on the plates were evaluated to assess the tolerance of the L. casei and L. casei ΔPyrR strains to 5-FOA.
4.7. Fermentation and Detection of Metabolic Production
Fermentation was carried out with 10 mL of MRS media in 250 mL Erlenmeyer flasks. The L. casei and L. casei ΔPyrR strains were statically cultivated in MRS media at an initial density of OD600 of 0.05. The cells of the cultures were incubated at 37 °C without shaking for 24 h. The suspensions and cells of L. casei and L. casei ΔPyrR were quantified via high-performance liquid chromatography (HPLC) to study metabolic production. The samples were obtained through using the following conditions: All samples and precooled buffers (20% H2O, 40% methanol, 40% acetonitrile v/v) were mixed together via ultrasonication in an ice bath for 30 min. The separations were centrifuged for 30 min at 12,000 rpm and at 4 °C. All of the samples were vacuum-dried and subsequently resolved using a 100 μL solution (50% H2O, 50% acetonitrile v/v).
The raw data from the LC-MS data were directly preprocessed using the Progenesis QI software 2.0 to facilitate an automatic search of the selected databases. Data from the positive and negative modes were mixed and processed together for a further multivariate statistical analysis that included sample names, peak intensity, retention time (RT), compound molecular weight, and metabolite identification.
4.8. Antibacterial Activity Assay
To investigate whether the L. casei and L. casei ΔPyrR strains could induce the damage and growth of pathogenic microorganisms, their antimicrobial activity was evaluated using the Oxford cup antibacterial experiment to determine the changes in the bacteriostatic activity of metabolic production and the lactobacillus body composition from the L. casei and L. casei ΔPyrR strains. Bacillus subtilis, Salmonella typhimurium, and Staphylococcus aureus were used as the indicator bacteria in the in vitro experiment. The indicator bacteria suspension was diluted to 108 cfu/mL, and 0.2 mL of each diluted bacterial culture suspension was inoculated on LB plates and evenly spread using a coater. Immediately afterwards, the Oxford cup method was performed by creating four vertical holes on the surface of the solidified LB medium, and 0.1 mL of each sample was added to each hole with PBS (negative control), antibiotics (positive control), a microbial supernatant, and a lactobacillus culture media composition in each plate of both the L. casei and L. casei ΔPyrR strains. Then, the Petri dishes were incubated at 37 °C for 10 h, and the diameter of the circular antibacterial zone was measured to determine the antagonistic activity of the microbial supernatant and lactobacillus body composition. The experiment was repeated three times under the same conditions to avoid the occurrence of errors.
4.9. Scanning Electron Microscopy Analysis of the Genome Editing of Lactobacillus casei
The morphological comparison of the genome editing of the Lactobacillus casei that deleted PyrR was further validated by microscopic analyses via the use of a scanning electron microscope (SEM) (Hitachi Limited, Tokyo, Japan). The control and deleting strains were cultured in an optical density at 37 °C without shaking. The samples were centrifuged and rinsed with 1× phosphate-buffered saline (PBS), fixed in a 2.5% glutaraldehyde solution that was buffered with 1× PBS, and incubated overnight. The next step was to dehydrate the samples with increasing concentrations of 20, 40, 60, 80, and 100% ethanol and then incubate them in 100% ethanol overnight at 4 °C. The dried samples were mounted on SEM stubs that were coated with a gold sputter for observation using a Quanta™ 250 FEG SEM (Thermo Fischer Scientific, Waltham, MA, USA). The SEM images were captured using PCI imaging software (Quartz Imaging Corp., Vancouver, BC, USA).
4.10. Fluorescent Tracking of Lactobacillus in Direct Contact with Macrophages
Briefly, the recombinant lactobacilli were grown in liquid MRS at 37 °C and washed three times with phosphate-buffered saline (PBS). The
L. casei and
L. casei ΔPyrR strains were stained with carboxyfluorescein diacetate and succinimidyl ester (CFDA-SE) for 30 min in 1 mL of CFDA buffer at 37 °C on a vertical rotator in a dark environment. To stain all of the cells, the lactobacilli were washed twice with 5 mL of PBS in order to remove excess CFDA-SE. The stained
L. casei and
L. casei ΔPyrR strains were resuspended into a single-cell suspension with 1 mL of a 1640-cell culture media. The peritoneal macrophages were collected as previously described [
35]. The mice were injected into the peritoneum with 5 mL of the 1640-cell culture media for peritoneal macrophage collection. The mice’s abdomens were gently rubbed for 2 min to enable the release of the peritoneal macrophages into the culture media from the abdominal cavity. The peritoneal fluid was sucked out and transferred into a tube, which was subsequently centrifuged for 5 min at 1000 r/min. Then, the macrophages were resuspended with the 1640-cell culture media, which contained 10% fetal calf serum, penicillin, and streptomycin, at 37 °C under a 5% CO
2 air atmosphere overnight.
To explore whether L. casei may promote the polarization of peritoneal macrophages via the pyrimidine production of the PyrR gene, we established the L. casei and L. casei ΔPyrR strains, as well as a peritoneal macrophage co-culture system, which was separately extracted from the mice. The CFDA-SE-labeled L. casei and L. casei ΔPyrR strains were contained inside the collected macrophages and cultured overnight in 12-well plates. After incubation at 37 °C under a 5% CO2 air atmosphere for 7 h, the plates were washed two times with pro-cold PBS and fixed with 4% paraformaldehyde for 30 min at RT. The wells were washed with pro-cold PBS and blocked with 1% BSA for 2 h at RT. F4/80+ served as a macrophage marker, which was used to measure the activity of the peritoneal macrophages with respect to the stimulation of pyrimidine production from the L. casei PyrR gene. The peritoneal macrophages were blocked via incubation with anti-F4/80 antibody binding for 30 min at RT in a dark environment. Then, the peritoneal macrophages were washed and stained with DAPI for 10 min, and images of them were captured via fluorescent microscopy (Leica Microsystems, Madrid, Spain).
4.11. Data Analysis
The metabolomics data were analyzed using different modules of the web-based platform MetaboAnalyst (
https://www.metaboanalyst.ca, accessed on 24 October 2022). The data were normalized using logarithmic transformation and auto-scaling. Fold change analysis and
t-tests were conducted to determine the fold change and significance of each identified metabolite. This process was performed in triplicate, and all of the groups were examined according to their independent measurements to adequately support the statistics and results derived from our experiments. The average recovery and colonization times over time were compared between groups using the repeated-measures analysis of variance model with Bonferroni’s correction using SPSS 26 software (IBM). Statistically significant effects (
p < 0.05) were further analyzed, and mean values were compared using Tukey’s significant difference test.